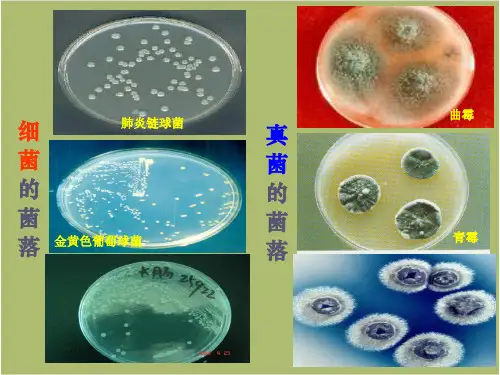

- 1、下载文档前请自行甄别文档内容的完整性,平台不提供额外的编辑、内容补充、找答案等附加服务。
- 2、"仅部分预览"的文档,不可在线预览部分如存在完整性等问题,可反馈申请退款(可完整预览的文档不适用该条件!)。
- 3、如文档侵犯您的权益,请联系客服反馈,我们会尽快为您处理(人工客服工作时间:9:00-18:30)。
3.细菌在适宜的条件下,每20~30分钟就可以繁殖一代,请估算 一下一个细菌在适宜的条件下一昼夜后会是多少。事实上细菌 的繁殖速度远远低于这个速度,你知道为什么吗? 提示:1×248~1×272个。因为得不到适宜的生活条件。
【分析】假如细菌每繁殖一次需要20~30分钟,一小时就会繁 殖2~3次,一昼夜24小时就会繁殖(2×24~3×24)次。由于细 菌繁殖是按2n进行(其中n代表繁殖次数),所以,一昼夜一个细菌 繁殖后的数量应为1×248~1×272个。实际上,细菌的繁殖速度 比理论上慢得多,也不会无限制地繁殖下去,因为细菌繁殖需要 适宜的环境条件(如水分、有机物、生存空间等),通常情况下, 这些条件是不会完全满足的,当外界条件不能满足细菌繁殖的全 部条件时,细菌就会停止繁殖。
第二节 细 菌
探究主题 一 细菌的发现
1.细菌的发现者:荷兰人_列__文__虎__克__,发现于17世纪后叶。 2.细菌来源的证明者:巴斯德 巴斯德证实细菌不是_____发生的,而是由__________________ 产称生 为的 “_。_他__还__发__现__了____自_”_然_。___、_______,提原出来了已巴经氏存消在毒的法细,菌被
可以通过___荚__膜度、过鞭不毛良环境
叶绿体 生理 分裂
芽孢
4.细菌与植物细胞的区别:细菌虽有_D_N_A_集中的区域,却没有 _____________。细菌没有_______,大多数细菌只能利用___ _成__形__的__细__胞__核生活,并把____叶__绿_分体解为简单的无机物。它们现是生
态成系的统有中机的物分解者。 有机物
【特别提醒】1.并不是每个细菌都有鞭毛,杆菌和螺旋菌一般有 鞭毛,球菌一般没有鞭毛。 2.并不是每个细菌都有荚膜。 3.有的细菌许多个生活在一起,如葡萄球菌,但是仍然彼此独立, 都是单细胞生物。
发现
__列____文____虎____克—__——发—现发其现来其源存在 微巴小斯德
需要___________观察
形态 一般结构:____________________________
细
特殊结高构倍:显_微__镜________
菌
没有_______细、胞异壁养、生细活胞膜、细胞质、DNA
结构 _____生殖
乳酸菌 酵母菌 微生物学之父
探究主题 二 细菌的形态、结构及与植物细胞的区别
1.大小:细菌的个体_________,要用_________________才能观
察到。
十分微小
高倍显微镜或电镜
2.形状:有_____、_____、_______等形态。
3.结构
杆形 球形 螺旋形
荚膜 细胞壁 细胞质
鞭毛 DNA 细胞膜
探究主题 三 细菌的生殖
1.细菌的生殖方式:_________。 2.细菌的适应方式:环分境裂条生件殖不适宜时,细菌个体形成休眠体 ——_____。细菌_________和_________的特性,使它们几乎 无处、不在。
芽孢
ห้องสมุดไป่ตู้
快速繁殖 形成芽孢
1.芽孢是细菌的生殖细胞吗?理由是什么? 提示:芽孢不是细菌的生殖细胞。因为一个细菌只能形成一个芽 孢,芽孢也只能萌发形成一个细菌,数目没有增加。 2.细菌在自然界中分布非常广泛,与它的哪些特点有关? 提示:(1)个体微小,极易被各种媒介携带; (2)进行分裂生殖,生殖速度快,数量多; (3)能形成芽孢,对不良环境有较强的抵抗力,而且还能四处飘散, 落在适宜的环境中,又能萌发形成细菌。